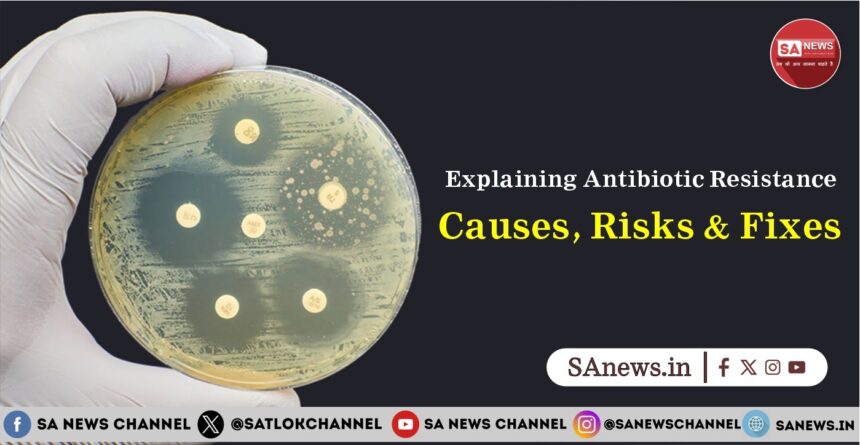
Explaining Antibiotic Resistance Causes, Risks & Fixes

Each of us is aware of bacterial diseases, whether strep throat, pneumonia, typhoid, or any other. There are high chances that most of us have caught these infectious diseases once or more in our lifetime. We also know how doctors prescribe antibiotics as medications for these diseases and remind us to complete the full dosage, or else the disease might strengthen, making it harder to treat.
We used to wonder why doctors emphasize completing the dosage. This is for two reasons: to help you recover timely and to avoid antibiotic resistance. Antibiotic resistance occurs when bacteria survive drug exposure, rendering treatments ineffective; it is one of the most severe risk factors in treating bacterial infections worldwide. Read the entire blog to learn about possible solutions to antibiotic resistance.
What Are Antibiotics?
Antibiotics are medications that either kill bacteria or inhibit their growth to treat bacterial infections, without harming human cells. They do this by targeting specific bacterial life processes such as cell wall formation, DNA synthesis, or protein production. Antibiotics can be further classified on the basis of chemical structure, mechanism of action, spectrum of activity, and bactericidal versus bacteriostatic effects.
Why Use Antibiotics?
Antibiotics are used to stop the growth of bacteria in case of many diseases ssuch as pneumonia, step throat and wounds, which was impossible otherwise. Antibiotics have helped in the treatment of many deadly diseases into treatable ones. They are providing help surgeries , chemotherapy as well as child birth.
Defining Antibiotic Resistance
Antibiotic resistance occurs when bacteria withstand the action of drugs designed to kill them, leading to treatment failure in diseases that were previously treatable. As a result, infections that were once treatable can become life-threatening challenges. Today, antibiotic resistance is emerging as a major global health crisis.
Causes of Antibiotic Resistance
Antibiotic resistance is a major health crisis worldwide. It is the combined result of human behaviours as well as environmental factors. Some major causes include:
- Overuse of Antibiotics in Healthcare: The overuse of antibiotics, even in the treatment of viral infections such as cough and cold, can lead to unnecessary exposure of bacteria to antibiotics and therefore causing antibiotic resistance.
- Misuse by Patients: Not completing the full course of the antibiotics leads to the antibiotic resistance amongst the bacteria surviving in the body. These bacteria then divide and multiply to form other antibiotic resistance bacteria, thereby worsening the situation of the patients.
- Agricultural Overuse: Regular antibiotics in the livestock farming creates superbugs which enter into the human body via the foodchain.
- Lack of New Antibiotics: Lack of discovery of new antibiotics and the ineffectiveness of the prevalent antibiotics prove to be ineffective against the antibiotic resistant bacteria.
- Global Travel: Rapid Movement of people and goods across the globe have further fueled antibiotic resistance.
Global Impact of Antibiotic Resistance
According to the World Health Organization (WHO), 1.27 million people lose their lives annually due to antibiotic resistance. This figure is increasing exponentially, with projections to reach 10 million lives lost per year by 2050, according to the WHO, if unchecked.
Antibiotic resistance is turning routine surgeries, cancer treatments, and childbirth procedures into life-threatening challenges. Superbugs such as multidrug-resistant tuberculosis and CRE are rendering traditional therapies ineffective, overwhelming hospitals and driving healthcare costs to trillions.
Also Read: How a Lab Mistake Led to the World’s First Antibiotic: Penicillin
Economically, due to antibiotic resistance, countries face productivity losses from high death tolls and illnesses. Low-income countries are worstv by the antibiotic resistance pandemic, increasing inequality and threatening global health security.
Strategies to Combat Antibiotic Resistance
Antibiotic resistance can be dealt with properly by taking measures at personal community, national as well as global levels.
- Antibiotic Stewardship Program: Hospitals adopt guidelines to ensure the prescription if antibiotics only in the case of confirmed bacterial infections, thereby reducing overuse and slowing antibiotic resistance development.
- Diagnostic Tests: Advanced tools distingudih between viral and bacterial diseases, which help in preventing unecessay antibiotic prescription.
- Fostering Patient Awareness: Educating patient to complete antibiotic drug course anc avoid taking antibiotics in case of viral or unknown infections, thereby reducing antibiotic resistance development.
- Limit Agricultural Use: Usage of alternatives such as vaccines and proper hygiene to reduce the risk of bacterial infections in livestock farming also helps to combat antibiotic resistance.
- Development of New Drugs: Incentives provided by governments and companies for the research and development of new, effective drugs help stay ahead of superbugs.
Hope Against Antibiotic Resistance
Despite the ongoing antibiotic resistance crisis, bright hopes exist in innovative solutions for overcoming antibiotic resistance, such as AI-assisted discovery of new drugs and revolutionary phage therapies that target superbugs with pinpoint accuracy.
New antimicrobials, point-of-care diagnostic tests, and vaccine solutions are being developed to prevent infections in the first place, while global programs like the WHO’s Global Action Plan promote responsible antibiotic use worldwide. With reduced overuse in agriculture and awareness programs in place, a brighter future beckons where antibiotic resistance can be controlled and managed.
When All the Treatment Fails, God Helps
We all are aware that God is the solution to everything. Whether it is our health, emotional or mental breakdown or financial issue. The scriptural proof for the power of Supreme God is mentioned in the Rigveda Mandal 9, Sukt 161 mentions that Supreme God can end all the diseases of His devotee and can grant the devotee age of 100 years.
The Supreme God mentioned in the Rigveda is none other than God Kabir Saheb. Currently true worship of Kabir Saheb ji available only with Saint Rampal Ji Maharaj. Readers are requested to take initiation from Saint Rampal Ji Maharaj to attain true way of worship to attain God Kabir Saheb and salvation.